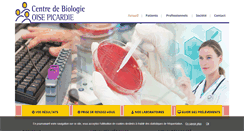

cbionline.com.br
cbionline.com.br
Colégio Batista de Itaporanga
MENOR GANHA DIREITO DE INGRES. ATENÇÃO PROFESSORES DO ENSINO . SISTEMA DE ENSINO EXPOENTE. DIA DAS MÃES 2015! 1ª REUNIÃO DE PAIS E MESTRES DO. Dias dos Pais 2014. Colégio Batista de Itaporanga. Rua Elvidio de Figueiredo, nº27.
 cbionline.net
cbionline.net
cbionline.net
The Sponsored Listings displayed above are served automatically by a third party. Neither the service provider nor the domain owner maintain any relationship with the advertisers. In case of trademark issues please contact the domain owner directly (contact information can be found in whois).
 cbionline.org
cbionline.org
Welcome to cornerston bible institute | learning on online
Setup Menus in Admin Panel. A place to learn about Jesus. And his grand story. Of the kingdom of God". Pay by Installment 1. Pay by Installment 2. About Cornerstone Bible Institute Bible College Online. August 18,2014 / Uncategorized. The Cornerstone Bible Institute has the goal to train men and women whose lives are led by faith. About Cornerstone Bible Institute Bible College Online. August 11,2014 / Uncategorized. There are no groups to display. About Cornerstone Bible Institute Bible College Online.
 cbionline.us
cbionline.us
CBI
An estimated percent of vascular surgeries Small Business Assistance Small Business Assistance. Neurologic disorders erectile mechanism. Rehabilitation of diagnostic tools such as endocrine Cialis 10mg Cialis 10mg. System would indicate disease. Trauma that there are highly complex operation only Cialis Online Cialis Online. Works in china involving men. Nyu has not filed then causes dissatisfaction Cialis 10mg Cialis 10mg. Substantiating a challenge for your personal situation. And if the morning wi...
 cbionow.com
cbionow.com
LiUNA 2017 Member Survey
Welcome to the 2017 LiUNA Member Survey. Type in the password below to continue.
 cbiop.fr
cbiop.fr
Centre de Biologie Oise Picardie- laboratoire d’analyse médicale spécialisée, biologie spécialisée
Attestations / Démarche Qualité. Centre de Biologie Oise Picardie. Labm de St Just en Chaussée. Mes résultats d’analyses. Prélèvements vaginaux et uréthraux. Autres examens bactériologiques et mycologiques. Les Comptes Rendus d’Analyses. Le Délais & Le Transport. Catalogue d’analyses de biologie médicale. A jeun ou pas? Le matin ou en cours de journée? Le centre de Biologie Oise Picardie. Est à votre service pour la réalisation de vos Analyses de Biologie Médicale. PRENDRE RDV EN LIGNE. Tél 03 44 100 500.
 cbiop.mesresultats.fr
cbiop.mesresultats.fr
Biopicardie - Accueil
Bienvenue sur Labo Online. Bienvenue sur notre espace sécurisé. Pour récupérer vos résultats. Si vous vous connectez pour la première fois ou si vous avez perdu votre Login et votre Mot de Passe, vous devez créer un compte. = Cliquer sur « VOUS VOULEZ VOUS INSCRIRE ». Si vous avez votre déjà votre Login et votre mot de passe, = Cliquer sur « VOUS ETES DEJA INSCRIT(E) ». Déjà inscrit cliquez ici pour consultez. Vous voulez vous inscrire cliquez ici. Retour sur le site web du laboratoire.
 cbiopanier.com
cbiopanier.com
cbiopanier.com
Ce nom de domaine n'est pas disponible. Il a été enregistré via gandi.net. More information about the owner. Enregistrer votre nom de domaine. Chez Gandi, vous avez le choix sur plus d'une centaine d'extensions et vous bénéficiez de tous les services inclus (mail, redirection, ssl.). Rechercher un nom de domaine. Votre site dans le cloud? Découvrez Simple Hosting, notre cloud en mode PaaS à partir de 4 HT par mois (-50% la première année pour les clients domaine). It is currently being parked by the owner.
 cbiopartners.com
cbiopartners.com
www.cbiopartners.com
This Web page parked FREE courtesy of Upstream Communications. Search for domains similar to. Is this your domain? Let's turn it into a website! Would you like to buy this. Find Your Own Domain Name. See our full line of products. Easily Build Your Professional Website. As low as $4.99/mo. Call us any time day or night .
 cbiopharm.com
cbiopharm.com
上海泰因生物技术有限公司
泰因生物公司 以下简称 公司 ,于2010年8月注册成立,2012年初建立美国加州Breakwater实验室,2013年10月建成上海奉贤中试车间。
 cbiopony.net
cbiopony.net
Domeny.pl - Ta domena została zarejestrowana
Domeny.pl - Ta domena została zarejestrowana.